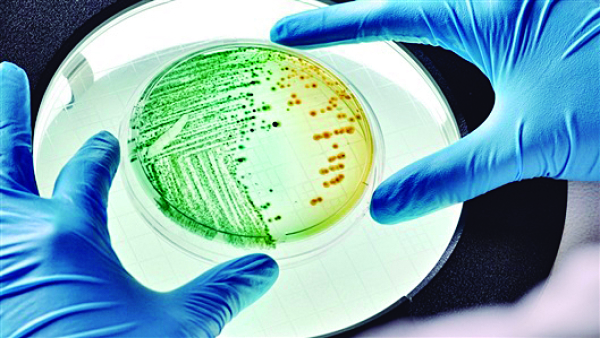

主要职责
中国科学院贯彻落实党中央关于科技创新的方针政策和决策部署,在履行职责过程中坚持党中央对科技工作的集中统一领导。主要职责是:
一、开展使命导向的自然科学领域基础研究,承担国家重大基础研究、应用基础研究、前沿交叉共性技术研究和引领性颠覆性技术研究任务,打造原始创新策源地。 更多+
院况简介
中国科学院是国家科学技术界最高学术机构、国家科学技术思想库,自然科学基础研究与高技术综合研究的国家战略科技力量。
1949年,伴随着新中国的诞生,中国科学院成立。建院70余年来,中国科学院时刻牢记使命,与科学共进,与祖国同行,以国家富强、人民幸福为己任,人才辈出,硕果累累,为我国科技进步、经济社会发展和国家安全作出了不可替代的重要贡献。 更多+
院领导集体
科技奖励
科技期刊
科技专项
科研进展/ 更多
工作动态/ 更多
工作动态/ 更多
中国科学院学部
中国科学院院部
语音播报
大肠杆菌将电脉冲转化成存储在其基因组中的DNA片段。图片来源:Sproetniek/iStock
“Hello World”是许多程序员的第一行代码,但你见过从生物活体内读出的“Hello World”吗?哥伦比亚大学的一个研究小组做到了,他们把数据写入活细菌的DNA。相关研究近日发表于《自然-生物化学》。
对数据存储而言,DNA在许多方面都很有吸引力。比如,相较于目前结构最紧凑的硬盘,DNA的密度是前者的1000倍以上,一粒盐大小的面积上能存储10部完整的数字电影。
随着时间推移,读取和写入DNA的技术终将迎来实用性更强、成本更低的那一天。但实际上,用DNA存储数据并不是个新点子。据《科学》报道,研究人员通常将二进制语言0和1转换为DNA的4个碱基AGCT(腺嘌呤、鸟嘌呤、胞嘧啶、胸腺嘧啶),再用合成器将代码写入DNA。
但这种方法也有缺点,DNA合成的准确性会随代码获取时间延长而降低,研究人员不得不将文件拆成多个部分,分别将其写入200~300个碱基长度的DNA片段内。为了标识在文件中的位置,再给这些片段加索引,当测序仪读取时得以重新组装。按该方法,1兆位信息合成的成本高达3500美元,而且存储着信息的DNA还会随时间降解。
一直以来,研究人员都在寻找更持久、更易于编码的方法。这次,研究人员将大肠杆菌及其携带的信息添加到正常土壤微生物的混合物中,通过对混合物测序,以获取先前存储的内容。
论文通讯作者、哥伦比亚大学系统生物学系的Harris H. Wang早在2017年就和课题组成员探索将数据写入生物体DNA的方法,曾利用基因编辑CRISPR系统识别生物信号,成功鉴定出果糖的存在。
当果糖被添加到大肠杆菌细胞中时,基因表达在质粒(一种环状DNA)中增加。接着,CRISPR系统中的成分进化为防御病毒入侵的细菌,将过表达的质粒切成碎片,并将其中一些放入细菌DNA的特定部分,以“记住”先前的病毒入侵者。插入的遗传位代表二进制里的1,如果没有果糖信号,细菌会存储随机的DNA片段以表示二进制中的0。对大肠杆菌DNA测序后,这些信息即可被读取。
之后,为了加大数据存储量,研究团队用电子输入替代了果糖识别系统。他们将一系列基因插入大肠杆菌,让细胞能响应电压、增加质粒表达。表达增加后,这些被数字化的表达物就能存进细菌DNA。为了读取存储内容,研究人员对细菌测序即可。
Wang表示,将数据存储在活的生物体中还为时过早,因此不会与当前的存储系统产生竞争。未来还需要改进办法,防止细菌复制时发生突变导致降解。
相关论文信息:https://doi.org/10.1038/s41589-020-00711-4
扫一扫在手机打开当前页
© 1996 - 中国科学院 版权所有 京ICP备05002857号-1
京公网安备110402500047号 网站标识码bm48000002
地址:北京市西城区三里河路52号 邮编:100864
电话: 86 10 68597114(总机) 86 10 68597289(总值班室)








